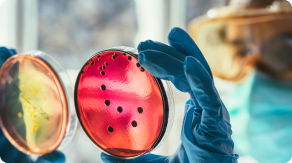
One Health Training

The Joint FAO–WHO-WOAH Global Early Warning System for health threats and emerging risks at the human–animal–ecosystem interface (GLEWS+)
Advancing one health intelligence to anticipate emerging risks and guide decisions
The names and classifications used for countries, territories and areas on this joint FAO-WHO-WOAH website may differ from those used in the respective materials of FAO, WHO and WOAH.
Learn. Research. Discover.
Official reports, interactive datasets, and curated resources supporting the analysis and understanding of emerging health risks linked to zoonotic and animal diseases worldwide

WHO EPI-WIN Webinar: Public health risk of avian influenza A(H5N1) detected recently in dairy cattle (6 May 2024)
WHO EPI-WIN Webinar: Public health risk of avian influenza A(H5N1) detected recently in dairy cattle (6 May 2024)

WHO Global Influenza Programme (GIP)
Weekly influenza trends, virology data, and global surveillance.

Public health risk assessment associated with the potential occurrence of zoonotic avian influenza A(H5N1) clade 2.3.4.4b in Latin-American and the Caribbean - 6 November 2024
Risk assessment for zoonotic H5N1 clade 2.3.4.4b in Latin America and the Caribbean.

WHO Health Emergency Dashboard
Real-time data on global health emergencies and ongoing crises.

EMPRES-i
EMPRES-i + is a web-based application that has been designed by FAO's Emergency Prevention System (EMPRES) to support veterinary services.It provides a centralized system for collecting, organizing, and accessing real-time animal disease data at national, regional, and global levels.

Biregional Advocacy Meeting on Risk Mitigation in Traditional Food Markets – Meeting Report
Meeting report on regional strategies for mitigating risks in traditional markets.

WHO EPI-WIN Webinar: Avian influenza H5 – an update (6 June 2024)
WHO EPI-WIN Webinar: Avian influenza H5 – an update (6 June 2024)

WHO Disease Outbreak News (DON)
Latest confirmed outbreaks and key public health updates from WHO.

FAO One Health webpage article Highlighting GLEWS+.
The Tripartite Global Early Warning System (GLEWS+) serves as an indispensable tool, facilitating the identification of shifts in disease patterns and enhancing our ability to proactively detect .

RRA
Rapid Risk Assessment MERS CoV

WHO Western Pacific: Avian Influenza Weekly Update # 1030: 23 January 2026
From 1 January 2003 to 19 December 2025, a total of 481 cases of human infection with avian influenza A(H5N1) virus have been reported from six countries within the Western Pacific Region.
The GLEWS+ dashboard does not provide a complete representation of all acute events and health threats at the human-animal interface that FAO, WHO, and WOAH are aware of and respond to. The events displayed represent only a subset of those reported through official channels, such as the FAO Global Animal Disease Information System (EMPRES-i), which supports veterinary services by organizing and providing access to regional and global disease information, or those reported through official channels, the International Health Regulations (IHR 2005), mandated by WHO, and the World Animal Health Information System (WAHIS), mandated by WOAH.
Differences in reporting and publication timelines across FAO, WHO, and WOAH may cause the same events to appear duplicated or to be reported later in some sources. Additionally, the disease situation in animals reported by WOAH-recognized official veterinary authorities in disputed areas may not be reflected on this map, but can be accessed here: https://wahis.woah.org/#/home.
This dashboard is intended for general information only.
The designations employed and the presentation of the material in this publication do not imply the expression of any opinion whatsoever on the part of FAO, WOAH or WHO concerning the legal status of any country, territory, city or area or of its authorities, or concerning the delimitation of its frontiers or boundaries. This designation is at variance with that used by WOAH and FAO ( which use Chinese Taipei and Taiwan, Province of China, respectively) in their materials. Dotted and dashed lines on maps represent approximate border lines for which there may not yet be full agreement.